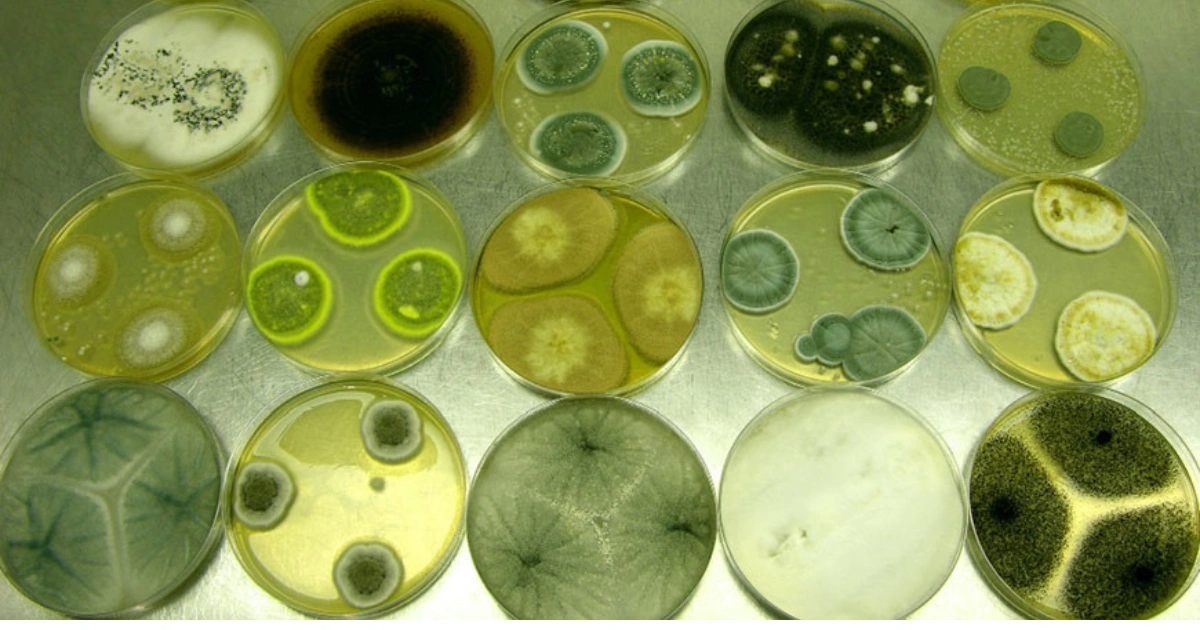

Diferencias entre rot, decay, spoil y mold: guía fácil para no confundirte
Aprender vocabulario en inglés puede ser más sencillo cuando entiendes las diferencias reales entre palabras similares. Hoy aclaramos las diferencias entre rot, decay, spoil y mold, cuatro términos relacionados con deterioro o descomposición, pero que no significan exactamente lo mismo.
Con ejemplos claros y reglas simples, podrás usarlos correctamente en conversaciones y textos.

🍎 Rot: descomposición avanzada con mal olor
Rot se refiere a la descomposición profunda de materia orgánica, especialmente alimentos o madera.
Se usa cuando algo está:
- Muy descompuesto
- Blando o podrido
- Con olor fuerte y desagradable
Ejemplos:
- The fruit began to rot in the heat.
- The wood started to rot after the rain.
Idea clave: si algo está completamente podrido, es rot.
🦷 Decay: deterioro lento y progresivo
Decay implica un proceso gradual de deterioro, no necesariamente inmediato ni siempre con mal olor.
Se usa en contextos como:
- Caries dental
- Deterioro de edificios
- Desgaste natural de plantas
Ejemplos:
- Tooth decay is caused by bacteria.
- The building showed signs of decay.
Idea clave: si es un desgaste lento y progresivo, es decay.
🥛 Spoil: alimento que pierde frescura
Spoil se usa principalmente para alimentos que se echan a perder o pierden frescura.
No siempre implica descomposición avanzada, sino que ya no es seguro o agradable consumirlo.
Ejemplos:
- The milk will spoil if left outside.
- The food spoiled overnight.
Idea clave: si la comida ya no está fresca, es spoil.
🍞 Mold: hongo visible en superficies
Mold se refiere específicamente al moho, un tipo de hongo que aparece en alimentos o superficies húmedas.
Se identifica visualmente.
Ejemplos:
- There is mold on the bread.
- Mold grows in damp places.
Idea clave: si ves hongos visibles, es mold.
Cómo diferenciarlos fácilmente
Aquí tienes una guía rápida para recordar:
1️⃣ Si huele fuerte y está completamente podrido → rot
2️⃣ Si es deterioro lento y natural → decay
3️⃣ Si la comida perdió frescura → spoil
4️⃣ Si ves moho visible → mold
Pequeños matices cambian completamente el significado.
Tabla comparativa rápida
| Palabra | Uso principal | Ejemplo típico |
|---|---|---|
| Rot | Descomposición avanzada | Fruta podrida |
| Decay | Deterioro progresivo | Caries dental |
| Spoil | Alimento echado a perder | Leche fuera del refrigerador |
| Mold | Hongo visible | Pan con moho |
Errores comunes al usar estas palabras
- Usar rot para comida simplemente pasada (mejor usar spoil).
- Confundir decay con rot cuando no hay descomposición avanzada.
- Pensar que mold es sinónimo general de deterioro (solo aplica a hongos).
Comprender el contexto es esencial.
Preguntas frecuentes sobre rot, decay, spoil y mold
¿Rot y decay significan lo mismo?
No exactamente. Rot es más avanzado y visible; decay es más gradual.
¿Spoil solo se usa con comida?
Principalmente sí, aunque también puede usarse en sentido figurado.
¿Mold siempre es dañino?
Algunos tipos pueden ser perjudiciales, especialmente en alimentos.
¿Decay puede usarse para personas?
Sí, en sentido figurado (por ejemplo, “moral decay”).
¿Cómo mejorar mi vocabulario en inglés?
Practica con ejemplos reales y aprende palabras por contexto.
Consejos para ampliar tu vocabulario en inglés
- Aprende palabras en grupos temáticos.
- Usa ejemplos en frases completas.
- Escucha contenido en inglés con subtítulos.
- Practica escribiendo oraciones propias.
La constancia es la clave para avanzar.
Sugerencias de enlazado interno (trucosdevida.com)
Puedes complementar este contenido con:
- Consejos para aprender inglés más rápido
- Técnicas para mejorar tu memoria
- Métodos prácticos para estudiar idiomas
Estos artículos refuerzan el aprendizaje continuo.
Conclusión
Entender las diferencias entre rot, decay, spoil y mold te ayudará a comunicarte con mayor precisión en inglés. Aunque todas se relacionan con deterioro, cada una tiene un matiz específico.
Prestar atención a pequeños detalles marca una gran diferencia en el significado.